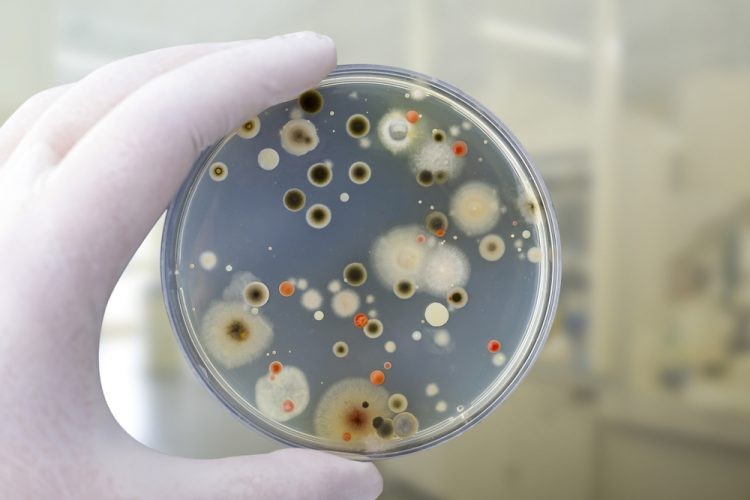

Lead Testing Why It Matters and How It's ...
Lead Testing: Why It Matters and How It's Done
Understanding Hazmat Surveying Protectin ...
Understanding Hazmat Surveying Protecting People, Property, and the Planet
The Importance of Asbestos Testing What ...
The Importance of Asbestos Testing: What You Need to Know